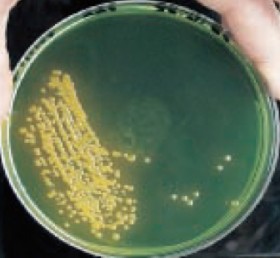
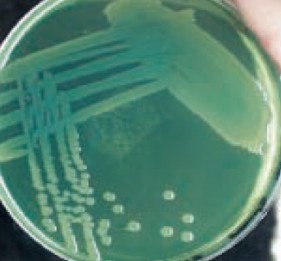

MỞ ĐẦU
1 Tính cấp thiết của đề tài
Nuôi tôm nước lợ là một hình thức nuôi quan trọng đem lại giá trị kinh tế cao, chiếm hơn 40% tổng giá trị sản phẩm nuôi trồng thủy sản ở nước ta. Trong các loài được nuôi ở nước lợ, tôm sú và tôm thẻ chân trắng là những loài được nuôi phổ biến trên địa bàn cả nước ta với gần 80% tổng diện tích nuôi trồng nước lợ (FAO, 2012). Hình thức nuôi này đóng một vai trò to lớn trong tổng giá trị nuôi trồng thủy sản tiêu thụ trong nước cũng như giá trị xuất khẩu sang nhiều nước trên thế giới.
Tuy nhiên, người nuôi tôm nước lợ đang phải đối mặt với nhiều loại dịch bệnh nguy hiểm gây thiệt hại lớn, trong đó phải kể đến bệnh hoại tử gan tụy cấp (AHPND). Đây là một loại dịch bệnh mới xuất hiện ở nước ta từ giữa năm 2010, gây chết tôm sú và tôm thẻ chân trắng hàng loạt trên địa bàn Đồng bằng song Cửu Long. Trong 2 năm tiếp theo, 2011 và 2012, dịch bệnh tiếp tục lan rộng ra nhiều tỉnh khác, tập trung tại Trà Vinh, Sóc trăng, Kiên Giang và ở một số tỉnh ven biển phía Bắc: Hải Phòng và Quảng Ninh, Bắc Trung bộ: Thanh Hóa và Nghệ An, Nam Trung bộ: Quảng Ngãi, Bình Định, Khánh Hòa, Ninh Thuận và Bình Thuận. Do diện tích tôm mắc bệnh rất lớn và tôm chết tập trung chủ yếu ở giai đoạn 20 - 30 ngày tuổi, đây là cỡ tôm khi phát hiện bệnh người nuôi thường xử lý và xả bỏ nên gây thiệt hại rất lớn. Đặc biệt trong năm 2012, cả nước có khoảng 100.776 ha diện tích nuôi tôm nước lợ bị thiệt hại do dịch bệnh thì có tới 46.093 ha diện tích nuôi tôm nước lợ được xác định là bị chết do hội chứng hoại tử gan tụy (Tổng cục Thủy sản, 2012).
Trong thời gian qua, đã có nhiều nghiên cứu được thực hiện nhằm xác
định nguyên nhân gây dịch bệnh. Một số nghiên cứu chỉ ra rằng hội chứng
này có liên quan trực tiếp đến thuốc bảo vệ thực vật và tảo độc, trong khi đó, một số nghiên cứu khác lại cho rằng có mối quan hệ chặt chẽ giữa việc sử dụng thức ăn và các chế phẩm sinh học trong nuôi trổng thủy sản với hội chứng hoại tử gan tụy. Tuy nhiên, nhiều nghiên cứu gần đây tìm thấy nhiều loại vi khuẩn ở tôm bị hội chứng hoại tử gan tụy cấp ở tất cả các vùng nuôi tôm trong đó vi khuẩn Vibrio chiếm thành phần chủ yếu và phổ biến nhất là các loài V. parahaemolyticus, V. vulnificus,V. harveyi. Cụ thể là, một nghiên cứu của giáo sư Lightner và cộng sự (2013) đã chỉ ra một chủng vi khuẩn V. parahaemolyticus là tác nhân gây ra hội chứng này.
Với mục đích làm rò sự liên quan của nhóm vi khuẩn Vibrio đến bệnh hoại tử gan tụy cấp, chúng tôi tiến hành đề tài: “Nghiên cứu khả năng gây bệnh hoại tử gan tụy cấp của một số loài vi khuẩn vibrio trên tôm nuôi nước lợ tại một số tỉnh phía Bắc”. Đây là một đề tài nhỏ thuộc đề tàii “Nghiên cứu nguyên nhân, tác nhân gây hội chứng hoại tử gan tụy trên tôm sú và tôm thẻ chân trắng và biện pháp khắc phục” của Bộ Nông nghiệp và Phát triển Nông thôn giao cho Viện nghiên cứu Nuôi trồng thủy sản 1 chủ trì trong năm 2013.
2 Mục tiêu nghiên cứu
Xác định các loài vi khuẩn Vibrio độc lực trên tôm sú, tôm thẻ chân trắng bị AHPND.
3 Nội dung nghiên cứu
- Xác định sự có mặt của vi khuẩn trên tôm bị AHPND
- Xác định các chủng vi khuẩn Vibrio độc lực
- Thử kháng sinh đồ đối với các chủng Vibrio độc lực xác định được
Chương 1: TỔNG QUAN TÀI LIỆU
1.1 Một số đặc điểm về đối tượng nghiên cứu
1.1.1 Đặc điểm phân loại và hình thái vi khuẩnVibrio
Hệ thống phân loại (Ackermann, 1984): Ngành Proteobacteria
Lớp Gammaproteobacteria
Bộ Vibrionales
Họ Vibrionaceae Veron, 1965 Giống Vibrio Pacini, 1854
Loài Vibrio spp
Hình thái:
Đặc điểm chung của các loài vi khuẩn thuộc giống Vibrio: Gram âm, hình que thẳng hoặc hơi uốn cong, kích thước 0,3-0,5x1,4-2,6 m; chúng không hình thành bào tử và chuyển động nhờ một tiêm mao hoặc nhiều tiêm mao mảnh.


Hình 1.1:Vi khuẩn V. parahaemolyticus Hình 1.2: Vi khuẩn V. vulnificus
(Buller, 2004) (Buller, 2004)


Hình 1.3: Vi khuẩn V. harveyi
(Buller, 2004)
1.1.2 Đặc tính phân bố và nuôi cấy
Hình 1.4: Vi khuẩn V. alginolyticus
(Buller, 2004)
Ngoài tự nhiên vi khuẩn Vibrio phân bố rất phổ biến trong môi trường nước biển và vùng nước lợ ven biển; có thể tìm thấy chúng trong các tầng nước, vùi trong trầm tích đáy hoặc bám trên bề mặt của các sinh vật sống trong vùng nước đó. Vibrio là vi khuẩn đặc trưng cho vùng nước biển ấm, phát triển mạnh ở nhiệt độ 20-300C (Bùi Quang Tề và cộng sự, 2004).
Trong môi trường nuôi cấy tất cả các loài vi khuẩn thuộc giống Vibrio đều cần muối NaCl để phát triển, nồng độ muối cho phép trong môi trường nuôi cấy thường là 1-2 %.
TCBS là môi trường chọn lọc của các loài vi khuẩn Vibrio, sau 18-24h nuôi cấy hình thành khuẩn lạc với kích thước khoảng 2–5mm, có màu vàng (V. cholerae, V. alginolyticus, V. fluvialis) hoặc xanh (V. parahaemolyticus,
V. harveyi, V. vulnificus).

Hình 1.5: Khuẩn lạc vi khuẩn
V. harveyi (Buller, 2004)
Hình 1.6: Khuẩn lạc vi khuẩn
V. Parahaemolyticus (Buller, 2004)
1.1.3 Đặc tính sinh hóa
Các loài vi khuẩn thuộc giống Vibrio đều yếm khí tuỳ tiện, hầu hết là oxy hoá và lên men trong môi trường O/F Glucose, không có khả năng sinh H2S và mẫn cảm với Vibriostat (0/129) (Bùi Quang Tề và cộng sự, 2004).


Hình 1.7: Nhuộm gram vi khuẩn
V.Vulnificus (Buller, 2004)
Hình 1.8: Phản ứng Indol trên
V. parahaemolyticus (Buller, 2004)
Bên trái: (-); Bên phải: (+)
Bảng 1.1. Đặc điểm sinh hoá của một số loài vi khuẩn Vibrio spp là tác nhân gây bệnh ở động vật thuỷ sản (Buller, 2004)
1 | 2 | 3 | 4 | 5 | 6 | |
Nhuộm Gram | - | - | - | - | - | - |
Di động | + | + | + | + | + | + |
Phản ứng Oxydase | + | + | + | + | + | + |
Phát sáng | + | + | - | - | - | - |
Phát triển ở nhiệt độ 40C | - | - | - | - | - | + |
Phát triển ở 370C | + | + | + | + | + | - |
Phát triển ở 0%NaCl | - | - | - | - | - | - |
Phát triển ở 3%NaCl | + | + | + | + | + | + |
Phát triển ở 7%NaCl | + | + | + | - | - | - |
Nhậy cảm 0/129 (10 g) | S | S | R | S | S | S |
Nhậy cảm 0/129(150 g) | S | S | S | S | S | S |
Màu khuẩn lạc trênTCBS | xanh | xanh | vàng | vàng | xanh | - |
Thử O/F Glucose | +/+ | +/+ | +/+ | +/+ | +/+ | +/+ |
galactosidase | - | + | + | - | ||
Arginine dihydrolase | - | - | - | - | - | - |
Lysine Decarboxylase | + | + | + | - | + | - |
Orinithine Decarboxylase | + | - | + | - | - | - |
Phản ứng Citrate | + | - | d | + | + | - |
Phản ứng Urease | - | - | - | - | - | - |
Khử Nitrate NO3NO2 | + | + | + | + | + | - |
Indol | + | + | + | + | - | - |
Sinh H2S | - | - | - | - | - | - |
Methyl red | - | + | - | d | - | |
Voges-Proskauer (V-P) | - | - | + | + | - | - |
Dịch hóa Gelatin | + | + | + | + | + | - |
Axit hoḠArabinose | d | - | - | + | - | - |
Axit hoḠGlucose | + | + | + | + | + | + |
Axit hoḠInositol | - | - | - | - | - | - |
Axit hoḠMannitol | + | + | + | + | - | D |
Axit hoḠSalicin | - | - | - | - | - | - |
Axit hoḠSorbitol | - | - | + | - | - | |
Axit hoḠSucrose | - | - | + | + | - | - |
Có thể bạn quan tâm!
-
Nghiên cứu khả năng gây bệnh hoại tử gan tụy cấp của một số loài vi khuẩn vibrio trên tôm nuôi nước lợ tại một số tỉnh phía Bắc - 1 -
Nghiên cứu khả năng gây bệnh hoại tử gan tụy cấp của một số loài vi khuẩn vibrio trên tôm nuôi nước lợ tại một số tỉnh phía Bắc - 3 -
Tình Hình Hội Chứng Gan Tụy Cấp Trên Tôm Nuôi Nước Lợ -
Phân Lập Và Định Danh Vi Khuẩn (Frerichs Và Millar (1983, 1993))
Xem toàn bộ 65 trang tài liệu này.
Chú thích:
1 - Vibrio parahaemolyticus 4 - Vibrio anguillarum
2 - Vibrio harveyi 5 - Vibrio vulnificus
3 - Vibrio alginolyticus 6 - Vibrio salmonicida
" + "> 90 % các chủng phản ứng dương " - " < 90 % các chủng phản ứng âm
“ d " 11 - 89 % các chủng phản ứng dương “ R ": Không mẫn cảm
“ S ": Mẫn cảm
n: Chưa có số liệu.
1.2 Tình hình nghiên cứu bệnh do vi khuẩn Vibrio spp trên tôm
1.2.1 Trên thế giới
Dịch bệnh xảy ra và những thiệt hại to lớn của nó là động lực thúc đẩy sự quan tâm nghiên cứu của nhiều nhà khoa học và cùng với nhu cầu cấp thiết của nền sản xuất mà trong một thời gian ngắn, hàng loạt các thành tựu nghiên cứu bệnh tôm đã được công bố và áp dụng. Dựa vào tác nhân gây bệnh, các nhà khoa học chia bệnh thủy sản ra thành những bệnh chủ yếu sau: Bệnh do virus, bệnh do vi khuẩn, bệnh do nấm, bệnh do ký sinh trùng và một số bệnh do các yếu tố vô sinh gây ra ở tôm.
Trong số các tác nhân gây bệnh ở tôm nuôi thì vi khuẩn là một trong những tác nhân thường gặp, được coi là có ảnh hưởng kinh tế rất lớn tới các trang trại nuôi tôm trên toàn thế giới (Venkateswara Rao và cộng sự, 2010). Trong điều kiện ao nuôi có mật độ cao, đầu tư thức ăn lớn, hiện tượng ô nhiễm thường xuyên xảy ra tạo điều kiện thuận lợi cho vi khuẩn phát triển và gây tác hại. Theo thống kê của Sindermann và Lighter (1988), các bệnh ở tôm do vi khuẩn gây ra chiếm 45,5% trong tổng số các loại bệnh, trong khi virus




